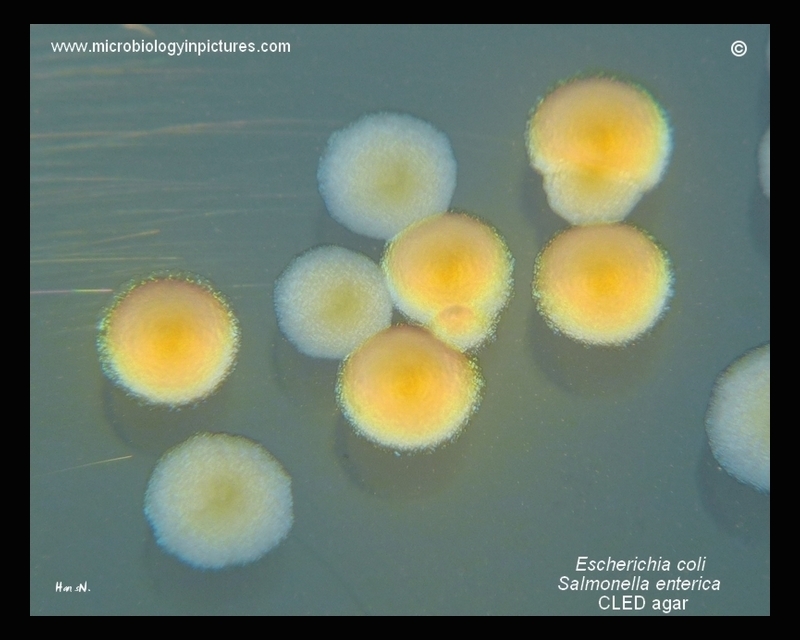

Enteric bacteria on CLED agar. Bacteria who utilize lactose form yellow colonies on CLED (typically E.coli, Klebsiella pneumoniae, Enterobacter cloacae). Bacteria who don't utilize lactose (typically Salmonella spp., Shigella, Proteus spp.) form blue-green colonies on the surface of CLED agar.
In the picture you can see yellow lactose-positive colonies of E.coli and blue-green lactose-negative colonies of Salmonella enterica.
Cultivation 24 hours, 37°C in an aerobic atmosphere.